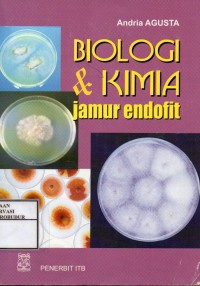
Image of Biologi & Kimia Jamur Endofit

Deprecated: trim(): Passing null to parameter #1 ($string) of type string is deprecated in /home/foux6592/public_html/library.borobudurpedia.id/lib/detail.inc.php on line 248
BUKU
Biologi & Kimia Jamur Endofit
Description Not Available
Availability
| BK00611 | 579 AGU b c.1 | Perpustakaan Balai Konservasi Borobudur | Available |
Detail Information
- Series Title
-
-
- Call Number
-
579 AGU b c.1
- Publisher
- Bandung : ITB., 2009
- Collation
-
110 hlm; 25 cm
- Language
-
Indonesia
- ISBN/ISSN
-
978-979-1344-42-5
- Classification
-
579
- Content Type
-
-
- Media Type
-
-
- Carrier Type
-
-
- Edition
-
-
- Subject(s)
-
-
- Specific Detail Info
-
Cet. Kesatu
- Statement of Responsibility
-
-
Other version/related
No other version available
File Attachment
No Data
Comments
You must be logged in to post a comment
 Computer Science, Information & General Works
Computer Science, Information & General Works  Philosophy & Psychology
Philosophy & Psychology  Religion
Religion  Social Sciences
Social Sciences  Language
Language  Pure Science
Pure Science  Applied Sciences
Applied Sciences  Art & Recreation
Art & Recreation  Literature
Literature  History & Geography
History & Geography